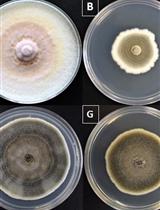
真菌对重金属的耐受指数的测定和重金属抗性试验

发布: 2016年12月20日第6卷第24期 DOI: 10.21769/BioProtoc.2080 浏览次数: 10430
评审: Valentine V TrotterEmilia Krypotou Sadri Znaidi
Abstract
Reactive oxygen species (ROS) are unavoidable by-products of aerobic metabolism. Despite beneficial aspects as a signaling molecule, ROS are principally recognized as harmful agents that act on nucleic acids, proteins and lipids. Reactive oxygen species, and, in particular, hydrogen peroxide (H2O2), are deployed as defense molecules across kingdoms, e.g., by plants in order to defeat invading pathogens like fungi. Necrotrophic plant pathogenic fungi themselves secrete H2O2 to induce host cell death and facilitate infection. Hydrogen peroxide is, to a certain extent, freely diffusible through membranes. To be able to monitor intracellular hydrogen peroxide dynamics in fungi, we recently established the versatile HyPer-imaging technique in the filamentous plant pathogen Fusarium graminearum (Mentges and Bormann, 2015). HyPer consists of a circularly permuted yellow fluorescent protein (cpYFP) inserted into the regulatory domain (RD) of the prokaryotic H2O2-sensing protein, OxyR. The OxyR domain renders the sensor highly specific for H2O2. Oxidation of HyPer increases fluorescence of cpYFP excited at 488 nm and decreases fluorescence excited at 405 nm, thereby facilitating ratiometric readouts (Belousov et al., 2006). HyPer turned out to be pH-sensitive. A single amino acid mutation in the H2O2-sensing domain of HyPer renders the sensor insensitive to H2O2. This reporter is called SypHer and serves as a control for pH changes.
By using the HyPer-imaging technique, we could demonstrate that: i) HyPer imaging enables the specific and accurate detection of rapid changes in the intracellular H2O2 balance, ii) F. graminearum reacts on external stimuli with the transient production of H2O2, and iii) faces increased H2O2 level during initial infection of wheat.
The aim of this protocol is to guide the user through the basic setup of an in vitro HyPer imaging experiment in basically any fungus. It will provide the specific parameter for the fluorescence imaging as well as the construction of customized flow chambers for in vitro applications.
Background
HyPer is a genetically encoded, highly specific H2O2 sensor protein enabling the real-time detection of fluctuations in the intracellular H2O2-level, e.g., in response to external stimuli. Genetically encoded sensors are advantageous over classical staining methods like 2’,7’-dichlorodihydrofluorescein diacetate (H2DCFDA), 3,3’-Diaminobenzidine (DAB), or boronate-based H2O2 probes since they lack the major disadvantages of the latter ones as for example technically sophisticated application, requirement for chemical fixation of cells, insufficient uptake, inadequate intracellular distribution of stains, and occasionally irreversibility (reviewed in Guo et al., 2014). A genetically encoded sensor widely used for in-vivo detection of redox states in a cell is the redox-sensitive GFP (roGFP) system. The roGFP system is, however, not specific to a certain subtype of oxidative agent, i.e., H2O2, but (indirectly) monitors the redox status of a cell.
Materials and Reagents
Equipment
Software
Procedure
文章信息
版权信息
© 2016 The Authors; exclusive licensee Bio-protocol LLC.
如何引用
Mentges, M. and Bormann, J. (2016). Highly Accurate Real-time Measurement of Rapid Hydrogen-peroxide Dynamics in Fungi. Bio-protocol 6(24): e2080. DOI: 10.21769/BioProtoc.2080.
分类
微生物学 > 微生物生物化学 > 其它化合物
微生物学 > 微生物生理学 > 胁迫反应
细胞生物学 > 细胞新陈代谢 > 其它化合物
您对这篇实验方法有问题吗?
在此处发布您的问题,我们将邀请本文作者来回答。同时,我们会将您的问题发布到Bio-protocol Exchange,以便寻求社区成员的帮助。
Share
Bluesky
X
Copy link